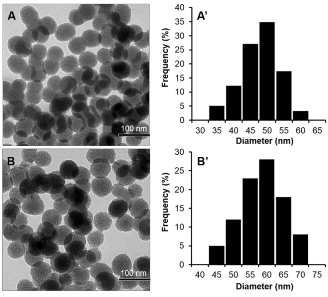
Hình 3 8 Ảnh TEM của PNS GPTMS A A’ và PNS GPTMS Hydrazine B B’ Phân tích kết 1

Qua phân tích ảnh TEM của PNS-GPTMS (A) và PNS-GPTMS-Hydrazine (B) ta thấy có dạng hình cầu có đường kính từ 35-60 nm và 45-70 nm đạt yêu cầu ứng dụng làm vật liệu dẫn truyền thuốc
Hình 3.8. Ảnh TEM của PNS-GPTMS (A, A’) và PNS-GPTMS-Hydrazine (B, B’) Phân tích kết quả phổ FTIR (hình 3.9):
Các đỉnh hấp thu tại 1083 cm-1 và 870 cm-1 mô tả dao động biến dạng của liên kết Si- O-Si thể hiện liên kết C-O của PNS.
Các dải dao động ở 3425 cm-1 thể hiện nhóm OH trên bề mặt PNS.
Trong phổ FTIR của PNS-GPTMS có đỉnh hấp thu rõ ở 917 cm-1 cho biết sự hiện diện của vòng epoxy chứng tỏ GPTMS đã gắn lên bề mặt của PNS[77, 78].
Đỉnh hấp thu ở khoảng 1600 cm-1 thể hiện dao động uốn cong của O-H có trong phân tử nước hấp phụ bởi vật liệu.
So sánh phổ FTIR của của PNS-GPTMS (b) và PNS-GPTMS-hydrazine (c) nhận thấy tín hiệu hấp phụ ở 917 cm-1 giảm đáng kể cho thấy hydrazine đã liên kết với GPTMS thông qua phản mở vòng epoxy [77].
Có thể bạn quan tâm!
-
Sơ Đồ Qui Trình Tổng Hợp Nano Silica Xốp (Pns) Bằng Phương Pháp Sol-Gel -
Biến Tính Pns Bằng Gelatin-Mpeg (Tổng Hợp Pns-Aptes-Cooh-Gel-Mpeg Hay Còn Gọi Là Pns -Gel-Mpeg Là Chất Mang Thuốc 5) -
Quy Trình Khảo Sát Hoạt Tính Gây Độc Bằng Phương Pháp Srb -
Phổ Ftir Của (A) Pns, (B) Pns-Aptes (C) Pns-Aptes-Cooh, (D) Gel- Mpeg, And (E) Pns-Gel-Mpeg -
Kết Quả Giải Phóng Thuốc 5-Fu Của Pns (Nano Silica Xốp) -
Phổ Hplc Của 5-Fu (A) Và Hplc Của Hệ Pns-Gptms-Cs-Mpeg Mang 5-Fu Giải Phóng (B)
Xem toàn bộ 137 trang tài liệu này.

Hình 3.9. FTIR của PNS (a), PNS-GPTMS (b) và PNS-GPTMS-Hydrazine (c)
3.2.1.2. Biến tính bằng Chitosan-mPEG (tổng hợp PNS-GPTMS-Chitosan-mPEG viết tắt PNS-GPTMS-CS-mPEG là chất mang thuốc 2)
Phân tích ảnh TEM
Qua phân tích ảnh TEM của PNS-GPTMS-CS-mPEG ta thấy hạt vẫn có dạng hình cầu phân bố đều đẹp, có đường kính từ trong khoảng 55-75 nm đạt yêu cầu ứng dụng làm vật liệu dẫn truyền thuốc.

Hình 3.10. Ảnh TEM của PNS-GPTMS –CS-mPEG
Phân tích kết quả phổ FTIR
Quan sát phổ FTIR của PNS và PNS-GPTMS ta thấy các dao động ở các số sóng như
sau:
Mũi hấp thu ở số sóng 1615 cm-1 thể hiện dao động uốn cong của nhóm –OH là dao
động của phân tử nước bị hấp phụ trong vật liệu.
Các dải dao động ở 3425 cm-1 thể hiện dao động kéo giãn nhóm -OH trên bề mặt PNS.
Các đỉnh nhỏ từ 2800 – 3000 cm-1 chỉ có trong phổ của PNS-GPTMS không có trong phổ PNS.
Các đỉnh hấp thu tại 1083 cm-1 và 870 cm-1 mô tả dao động biến dạng của liên kết Si- O-Si thể hiện liên kết C-O của PNS.
Trong phổ FTIR của PNS-GPTMS có đỉnh hấp thu ở 917 cm-1 cho biết sự hiện diện của vòng epoxy chứng tỏ GPTMS đã gắn lên bề mặt của PNS [78].
Các đỉnh hấp thu ở 2417 cm-1 và 2333 cm-1 thể hiện dao động biến dạng của C-H có trong PNS-GPTMS.
Quan sát phổ PNS-GPTMS-Chitosan-mPEG ta thấy xuất hiện tín hiệu ở số sóng 1736 cm-1 (amide I) và 1635 cm-1 (amide II) trong chitosan. Tín hiệu này đóng vai trò quan trọng trong việc kết luận đã gắn được Chitosan-mPEG lên hạt PNS-GPTMS [79].

Hình 3.11. Kết quả FTIR của a) Nano silica xốp (PNS); b)PNS-GPTMS; c) PNS-GPTMS– Chitosan-mPEG; d) Chitosan -mPEG
Phân tích bằng giản đồ TGA
Tiến hành đo TGA của 5,17 mg mẫu, gia nhiệt 10oC/phút đến 800oC trong khí quyển nitơ, ta thu được những nhận xét như sau:
Sự giảm khối lượng mẫu ban đầu là do hơi ẩm, khối lượng này chiếm một lượng không đáng kể. Trong khoảng nhiệt độ từ 264oC đến 280oC, có sự giảm khối lượng một cách đáng
kể khoảng 38,5%. Khối lượng tiếp tục giảm khi gia nhiệt lên đến 600oC, và cuối cùng mẫu bền nhiệt đến 800oC.
Tổng cộng trong 5,17 mg mẫu đem phân tích đã có sự giảm khối lượng đến 45,83% đồng nghĩa với việc giảm đi 2,35 mg. So sánh với giản đồ TGA của PNS-GPTMS, ta thu được những kết luận như sau:
Trong 9,12 mg PNS-GPTMS, có khoảng 1,76 mg 3-glydoxypropyl. Điều này đồng nghĩa với việc trong 5,12 mg mẫu PNS-GPTMS-CS-mPEG có khoảng 0,99 mg 3- Glydoxypropyl.
Như vậy với phép trừ đơn giản ta sẽ có khoảng 1,36 mg CS-mPEG có trong 5,12 mg mẫu.
Vậy qua giản đồ TGA ta thấy khẳng định thêm kết quả biến tính CS-mPEG trên PNS thông qua cầu nối GPTMS[79].

Hình 3.12. Giản đồ TGA của PNS-GPTMS (a) và PNS-GPTMS-Chitosan-mPEG (b)
Đường đẳng nhiệt hấp phụ BET (Brunauer-Emmett-Teller) của hệ PNS-GPTMS-Chitosan-mPEG
Đo BET để khảo sát diện tích bề mặt cũng như dự đoán được cấu trúc vật liệu. Từ đường hấp phụ đẳng nhiệt trên kết luận rằng vật liệu sau biến tính vẫn có cấp trúc xốp. Hệ nano silica xốp (PNS) sau khi biến tính bằng chitosan-mPEG có diện tích bề mặt là 91,38 m2/g. Mặc dù thấp hơn hệ chưa biến tính một chút do chitosan che chắn một phần bề mặt PNS tuy nhiên với diện tích bề mặt này vẫn khá tốt giúp ta củng cố hi vọng rằng vật liệu mới tạo ra sẽ giúp mang thuốc một cách hiệu quả.
3.2.2. Biến tính thông qua cầu nối APTES
Mặc dù (3-aminopropyl)triethoxysilane (APTES) được gắn lên PNS trở thành PNS- APTES dùng làm cầu nối trong quá trình biến tính PNS. Tuy nhiên, có một điều thú vị là PNS-APTES có nhóm amino (-NH2) nên cũng có khả năng mang DOX thông qua liên kết amine. Do đó, chúng tôi dùng PNS-APTES làm chất mang thuốc số 3 và khảo sát khả năng mang giải phóng.
3.2.2.1. Biến tính bằng gelatin (tổng hợp PNS-APTES-COOH-gelatin còn gọi PNS-APTES- COOH-GE (chất mang thuốc 4))
Phân tích kết quả phổ FTIR
Để chứng minh cho sự thành công khi biến tính từng bước các nhóm chức lên bề mặt PNS. Ta tiến hành đo từng mẫu trong cùng điều kiện và nhận thấy rằng:
Mũi hấp thu ở 1615 cm-1 là dao động uốn của OH của phân tử nước bị hấp phụ trong vật liệu.
Băng hấp phụ 3417 cm-1 tượng trưng cho dao động uốn cong của O-H trên bề mặt PNS. Đỉnh hấp thu tại 1093 cm-1 và 813 cm-1 mô tả dao động kéo giãn của Si-O-Si và Si-O. Đỉnh hấp thu tại 2417 cm-1 tương ứng với dao động kéo giãn của nhóm C-H.
Xem phổ (b); nhóm amino được thể hiện qua dao động đối xứng tại 1435 cm-1 và 860 cm-1 chứng minh APTES đã gắn lên bề mặt PNS.
Qua phổ (c) cho thấy khi PNS-APTES tạo liên kết hóa học với anhydrid succinic hình thành nên PNS-APTES-COOH hấp thu đặc trưng tại 1630 và 1560 cm-1
Phổ (d) cho thấy đỉnh hấp thu tại 1610 và 1541 cm-1 tương ứng với nhóm amino trong Gelatin [80].

Hình 3.13. FTIR của (a) PNS, (b) PNS-APTES, (c) PNS-APTES-COOH, (d) PNS- APTES- COOH-GE
Kết quả trên đã được so sánh đối chiếu với nghiên cứu của J. Zhang và cộng sự [81] thấy có sự tương đồng chứng minh gelatin đã biến tính thành công trên bề mặt PNS.
Kích thước hạt nano silicate biến tính bằng chụp TEM

Hình 3.14. Ảnh TEM của vật liệu nano silicate sau khi biến tính bằng gelatin
Qua hình ảnh TEM và phân bố kích thước của PNS-APTES-COOH-GE cho thấy hạt PNS sau biến tính bằng gelatin có dạng hình cầu, kích thước đồng đều trong khoảng 60- 70nm, với kích thước đó hạt có khả năng kéo dài thời gian lưu thông trong máu tránh sự hấp thu có chọn lọc ở gan, nhưng đủ nhỏ để tránh lọc cơ học bởi lá lách. Ngoài ra, kích thước trong khoảng (50 – 100nm) cho phép các hạt nano nhắm mục tiêu thụ động vào các tế bào
khối u thông qua hiệu ứng tăng tính thấm và duy trì (EPR), tăng cường tích lũy nội bào và định vị các hạt nano trong khu vực khối u [82].
3.2.2.2. Biến tính PNS bằng GEL-mPEG (tổng hợp PNS-APTES-COOH-GEL-mPEG hay còn gọi tắt là PNS-Gelatin-mPEG (chất mang thuốc 5)
Kích thước hạt nano silicate biến tính bằng chụp TEM
Từ TEM ta nhận thấy hệ sau khi biến tính vẫn ở dạng hạt hình cầu. So sánh với kích thước hạt PNS thì kích thước hạt PNS-Gelatin-mPEG tăng lên sau biến tính và đạt độ đồng đều tương đối cao. Kích thước PNS sau khi biến tính là 69,60±3,27 nm.

Hình 3.15. Ảnh TEM, sơ đồ phân bố kích thước hạt của vật liệu nano silicate trước biến tính(a,b) và sau biến tính bằng GEL-mPEG (c,d)
Phân tích nhiễu xạ tia X
Để tiến hành kiểm tra sự thay đổi về cấu trúc tinh thể của hạt nano silica sau khi biến tính bằng Gelatin-mPEG, nghiên cứu tiến hành phân tích nhiễu xạ tia X và thu được kết quả sau:
Hình 3.19 (a) có hai đỉnh nhiễu xạ cực đại xung quanh 3,4o và 6,8o đặc trưng cho lõi CTAB (Cetyltrimethylamnonium bromide). Sản phẩm được đo khi còn nguyên CTAB chưa ngâm hỗn hợp nano silica trong dung dịch acid acetic để rút lõi.
Hình 3.19 (b) có hai đỉnh nhiễu xạ cực đại trong khoảng 20o và 26o tương ứng với sự hiện diện của nano silica.
Hình 3.19 (c), giản đồ XRD của mẫu PNS-APTES-COOH-GEL-mPEG cho thấy sự tăng cường độ nhiễu xạ ở 26,9o và phản xạ mới xuất hiện ở 2θ là 23,2o; phản xạ yếu ở 26,9 o là do
liên hợp với GEL-mPEG góp phần chứng minh cho sự thành công của PNS-APTES- COOH-GEL-mPEG.

Hình 3.16. Giản đồ XRD góc nhỏ của (a) PNS (CTAB), (b) PNS-COOH, and (c) PNS-GEL- mPEG.
Giản đồ nhiễu xạ tia X của hạt nano PNS-Gelatin-mPEG tổng hợp được cho thấy sự xuất hiện của các mũi đặc trưng của nano silica 2θ = 22là phù hợp với cấu trúc xốp của hạt nano silica[83]. Trên giản đồ cũng xuất hiện mũi đặt trưng của PEG và gelatin.Kết quả thu được từ mẫu PNS-Gelatin-mPEG giống với mẫu của PNS. Điều đó cho thấy rằng sau khi được biến tính bởi Gelatin-mPEG, không ảnh hưởng tới cấu trúc hạt nano silica.
Phân tích kết quả phổ FTIR
Quan sát phổ IR, nhận thấy có cả các dao động của phổ PNS-COOH và phổ Gelatin- mPEG ở các bước sóng như sau:
- N-H dao động kéo giãn và N-H uốn cong lần lượt hấp thu ở bước sóng 3424 cm-1 và 1564 cm-1.
- C-H dao động kéo giãn đối xứng của PEG hấp thu ở bước sóng 2888 cm-1.
- Các đỉnh của Gelatin hấp thụ ở bước sóng: 2741 cm-1; 2696 cm-1; 842 cm-1; 1107 cm-
1;
- Các đỉnh nằm trong peak lớn đặc trưng của nano silica. Các peak hấp thu có bước sóng ở 462 cm-1, 530 cm-1, 1.061 cm-1 là của Si-O-Si. C-Si-O hấp thu ở bước sóng 961 cm-1.






